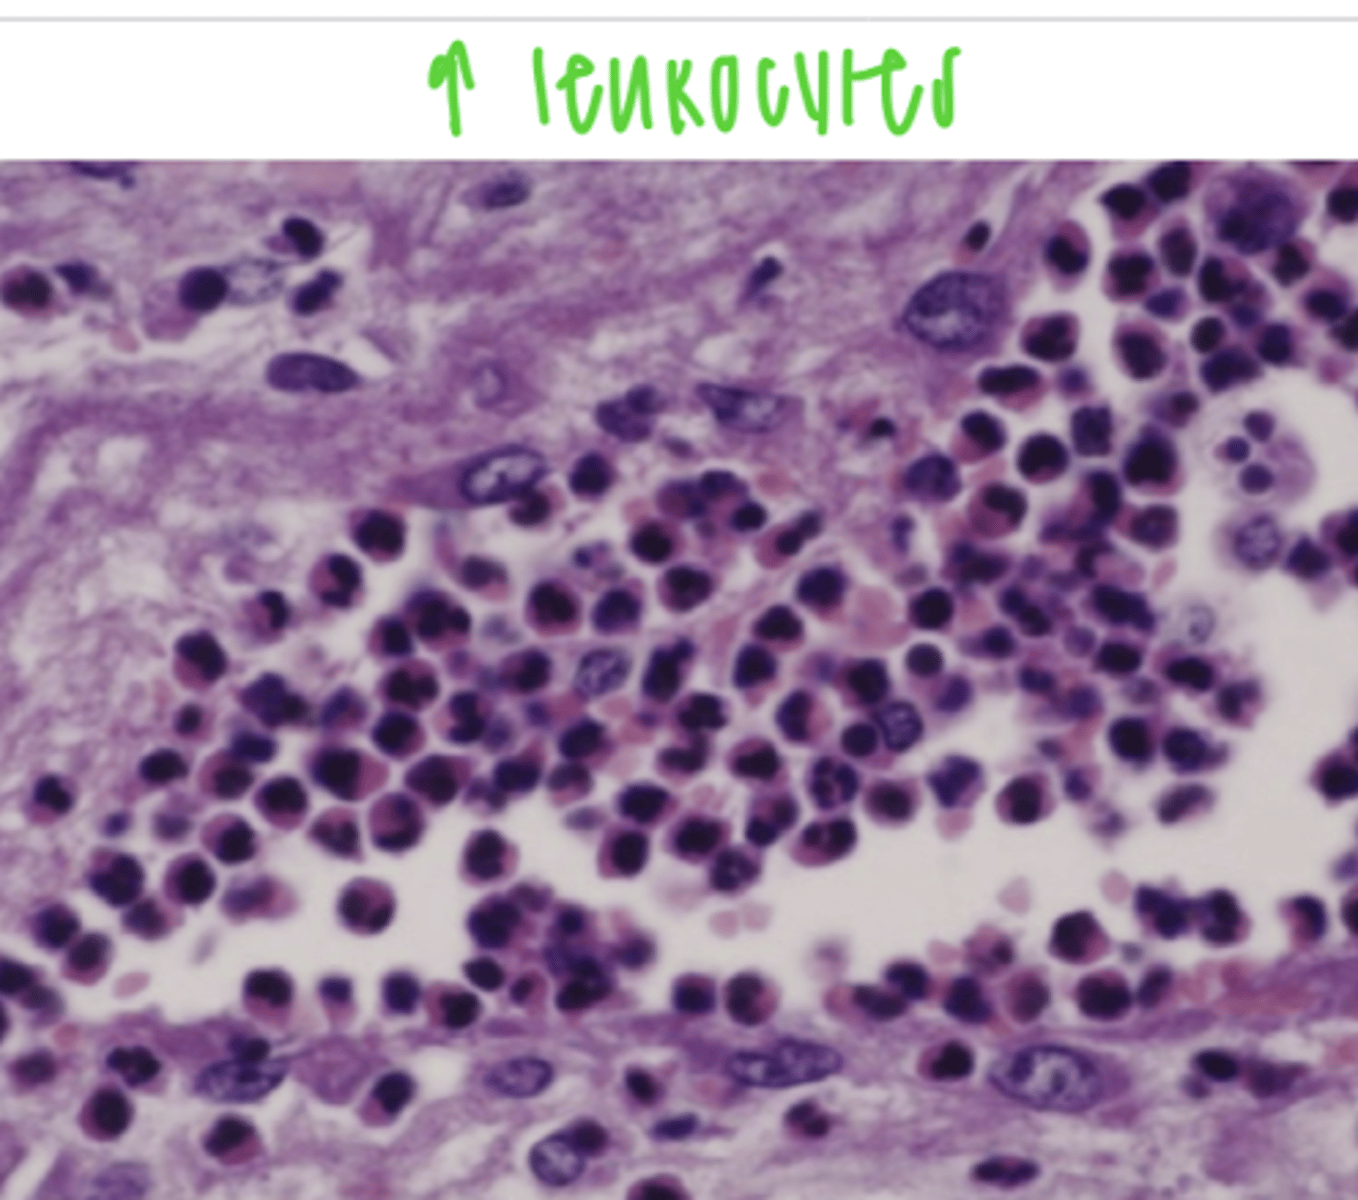
<p>acute active local hyperemia</p>

hyperemia, congestion, and hemorrhage
1/66
There's no tags or description
Looks like no tags are added yet.
Name | Mastery | Learn | Test | Matching | Spaced | Call with Kai |
|---|
No analytics yet
Send a link to your students to track their progress
67 Terms
hyperemia/congestion is....
the increase of blood in a specific area of the body
what are examples of physiological hyperemia?
blood supply increases in the GI tract during digestion
blood supply increases to muscles during exercise
blushing due to nervousness
how do we classify hyperemia/congestion?
type- active/passive
extension- local/generalized
duration-acute/chronic
what is the difference between active and passive hyperemia/congestion?
active- there is an increased blood flow and volume of arterial blood
passive- obstruction of venous outflow

what is active hyperemia?
the increase of blood in a specific area of the body due to an increased arterial blood flow

what is passive congestion?
the increase of blood in a specific area of the body due to a venous obstruction

what is acute active local hyperemia?
the increase of blood flow and volume of arterial blood due to chemicals that produce chemotaxis and vasodilation
ex- inflammation
how can we identify acute active local hyperemia?
grossly:
intense red color
increase in size
increase in temperature
microscopically:
dilation of blood vessels
presence of leukocytes

if macroscopically we see an organ that is very red, hot, and big, we can assume that what has occurred?
acute active local hyperemia

what type of vascular disorder shows an increase in the presence of leukocytes when looking at histological image?
acute active local hyperemia
where in the body acute passive local congestion more common?
in the GI system of dogs and horses
ex- intestinal torsion
how does acute passive local congestion appear?
dark red/purple
dilated vessels

if we perform a necropsy on a dog and observe very dark purple intestines, what can we guess has happened?
acute passive local congestion due to torsion

in an animal where intestinal torsion has occurred, what do we expect the organs to look like and why?
dark red/purple
because the intestinal torsion obstructs the venous outflow, causing acute passive local congestion

what is chronic passive local congestion?
the progressive obstruction of venous blood, due to abscesses, tumors, hepatic cirrhosis, etc.

what is the difference between acute and chronic passive local congestion?
acute- rapid obstruction of venous outflow, caused by torsion or a blockage
chronic- slow, progressive obstruction of venous outflow, caused by an abscess, tumor, hepatic cirrhosis, etc
what can cause chronic passive local congestion to occur?
a tumor, abscess, cirrhosis, etc.
what is chronic passive generalized congestion?
restriction of venous outflow due to cardiac lesions
chronic passive local congestion is caused by _________, while chronic passive generalized congestion is caused by ________
a tumor, abscess, cirrhosis, etc.; cardiac lesions
if the right heart is affected, in what organ will we notice chronic passive generalized congestion?
liver
if the left heart is affected, in what organ will we notice chronic passive generalized congestion?
lungs
if we notice chronic passive generalized congestion in the lungs, we can say that the cause is......
left heart lesion/failure

if we notice chronic passive generalized congestion in the liver, we can say that the cause is......
right heart lesion/failure

what might be a cause of chronic passive generalized congestion?
cardiac lesions:
valve stenosis or insufficiency

if we notice enlarged, dark lungs with foam in the trachea, what vascular disorder can we add to the differential diagnosis?
chronic passive generalized congestion due to left heart lesion/failure
how do the lungs appear if they have suffered chronic passive generalized congestion?
grossly:
enlarged
dark
foam in the trachea
microscopically:
dilated, blood filled capillaries
macrophages with hemosiderin
pulmonary edema
septal fibrosis

how does the liver appear if it has suffered chronic passive generalized congestion?
grossly:
enlarged
red and yellow- "nutmeg liver"
softer consistency
microscopically:
congestion and dilation of sinusoids
beginning of fat degeneration

what is "nutmeg liver"?
a red and yellow spotted liver due to chronic passive generalized congestion, caused by a right heart failure.

if we see a red and yellow spotted liver, and then when we take a biopsy we find sinusoid congestion and dilation, what is our diagnosis?
chronic passive generalized congestion, caused by a right heart failure

what is a hemorrhage?
the exit of blood from the vessels or heart
what are the 2 types of hemorrhage?
external and internal
what are the pathogenic mechanisms that cause a hemorrhage?
vascular rupture
alterations in vascular permeability
what is rexis?
the sudden rupture of a vessel, causing hemorrhage.
ex- cut with a knife
what is diabrosis?
a slow, corrosive rupture of a vessel
ex- microorganisms damaging vessel walls
what is diapedesis?
when erythrocytes can cross the vascular wall
it can be caused by hypoxia, drugs, vitamin C deficiency, or neurogenically
what is petechia?
small dots of blood, common in parenchymous organs

what is ecchymosis?
large hemorrage

if we find a linear ecchymosis, we can assume the cause is.....
parasitic migration

petechia and ecchymosis are both related to....
septicemia

ecchymosis is commonly the result of....
coagulopathies (issues with coagulation)
in small ruminants, what is the cause of petechia on the ribs?
copper intoxication

histologically, what does petechia look like?
RBCs outside of the vessels

during a necropsy, we see an animal with lots of blood in its organs.. how can we tell if it is just a coagulatory post-mortem change or if it was a pathological hemorrhage?
rinse with water- if just clotting, the blood will wash away. in a hemorrhage, it is in the organ parenchyma
what is a hematoma?
when there are so many hemorrhagic cells that they create an elevation. caused by trauma or coagulopathy

what is hemothorax?
hemorrhage, causing blood accumulation in the pleural cavity
what is hemopericardias?
accumulation of blood in the pericardial sac
what is hemoperitoneum?
accumulation of blood in the abdominal cavity
what is the medical term for hemorrhage in the joints?
hemoartros
what is a hematocele?
the accumulation of blood in the scrotum
what is purpura?
extensive petechial and ecchymotic hemorrhages in the serosa and mucosa, caused by platelet alterations (thrombocytopenia) or endothelial lesions
what is metrorrhagia?
purpura in the uterus (abnormal uterine bleeding)
what is epistaxis?
bleeding from the nose

what is the medical term for bloody vomit, due to lesions in the stomach or esophagus?
hematemesis
what is hemoptisis?
bleeding from the mouth, due to lung lesion

what is hematemesis?
bloody vomit due to lesion in the stomach or esophagus
what is gastrorrhagia?
gastric hemorrhage

what is rectorragia?
hemorrhage from the rectum, causing bright red feces
what is melena?
bleeding in the stomach, causing a black/dark red feces
what are the possible causes of hemorrhage?
-trauma
-septicemia, viruses, toxins
-alterations of coagulation mechanisms (hypothrombinemia, inherited deficiency of coag. factors, thrombocytopenia)
what is cumarine?
a toxin found in plants that can cause hemorrhage

what are possible consequences of hemorrhage?
some can create pressure that interferes with tissue function. this is most significant in vital organs or in tissue with little room to expand (brain and heart)
what is the consequence of hemorrhage in the CNS?
internal hemorrhages affect the brain parenchyma
intracraneal extraencephalic hemorrhage puts pressure on the brain tissue

why is an intraparenchymal hemorrhage dangerous for the heart?
because it puts pressure on the myocardium, causing death of the cells and/or conduction system
pericardial hemorrhages are called...
hemopericardium

what is the difference between an acute and chronic hemorrhage?
acute- rapid rupture of a large amount of blood; can cause death from hypovolemic shock
chronic- progressive output of a small amount of blood; can cause anemia
which is more severe/dangerous for the animal- acute or chronic hemorrhage?
acute, because it is the loss of a large volume of blood in a short amount of time, so the body does not have much time to adapt, which can lead to hypovolemic shock.
chronic hemorrhage is slower, so the body can adapt by increasing RBC production- it can lead to anemia, but is survivable

after the body has a hemorrhage, what can it do to get rid of the blood?
reabsorption- if it is a small amount of blood, macrophages with phagocytize it and are loaded with hemosiderin,
reorganization- if it is a large amount of blood, the hematoma is surrounded by a fibrous CT capsule and macrophages with enter to phagocytize it
